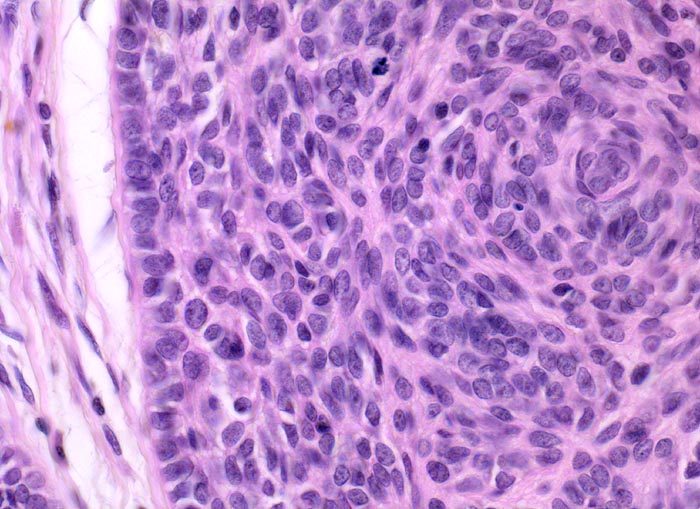

PathoPic – image database / PathoPic ID 5103 - Basaliom
de
Diagnose
Basaliom
Diagnose Gruppe
maligner Tumor
Topographie
Haut, Kopf
Topographie Gruppe
Haut
Beschreibung
Solider Tumor. Die Tumorzellen sind am Rand der Zellplatte parallel ausgerichtet, im Zentrum liegen sie ungeordnet und bilden einen angedeuteten Wirbel. Die Tumorzellkerne sind leicht hyperchromatisch und recht monomorph. Spärlich vorhandenes basophiles Zytoplasma und unscharfe Zellgrenzen. Retraktionsartefakt zwischen Tumor und Stroma.
Klinik
Derber weisser, leicht erhabener Knoten an der Nase.
Bilder Typ
Histologie
Vergrösserung
400
Alter
83
Geschlecht
unbekannt
Datum
Ersteintrag: 08.07.2002
Update: 04.02.2024